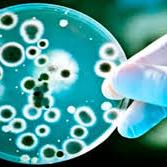

Mudanças climáticas podem causar a extinção de sapos e demais anfíbios
As altas temperaturas também podem causar sofrimento ao animal que, por transpirar pela pele, tem aumento expressivo de perda de água do corpo
Um estudo publicado na revista Nature, feito pela Avaliação Global de Anfíbios (GAA2), em 2022, mostrou que dentre os animais vertebrados, os anfíbios são os que mais estão ameaçados de extinção, com um aumento de mais de oito mil espécies em risco comparado ao último levantamento, feito em 2004.
VEJA MAIS
Principais causas da extinção gradual dos anfíbios
Conforme diz a pesquisa, 91% dos riscos de extinção desses animais correspondem a difusão de doenças e perda do habitat natural, sendo estes os principais motivos da problemática. Já as alterações climáticas correspondem a 39%.
A perda do habitat representa um risco expressivo, cerca de 37%, concluindo que são necessárias medidas de conservação e controle, principalmente as relacionadas com as mudanças de clima.
Desmatamento também é uma causa negativa
Com relação à perda do habitat, a agricultura aliada ao desmatamento representa um perigo de 77% para as espécies. A extração de madeira aparece com 53%; a modificação da paisagem para a infraestrutura urbana, com 40%.
Aquecimento global além da ameaça de extinção, causa sofrimento a esses animais
Por serem animais que usam a pele para respirar, os anfíbios apresentam uma maior tendência de perder água e calor, e com o aumento das temperaturas, são vistos como os animais que mais sofrem com as mudanças.
Além das mudanças de clima, as secas prolongadas contribuem para o fator de risco.
*Carolina Mota, estagiária sob supervisão de Tainá Cavalcante, editora web de OLiberal.com
Palavras-chave
COMPARTILHE ESSA NOTÍCIA